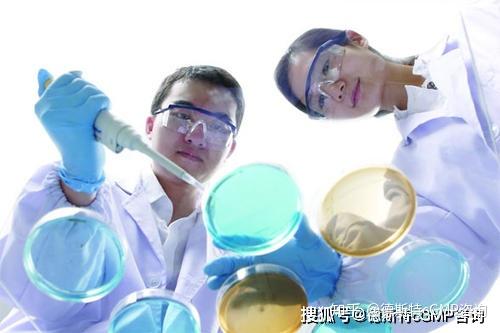

锅炉百科知识大全

中国垃圾焚烧炉行业现状分析及发展规模预测报告2021-2027年

2022年垃圾发电行业研究报告

关于生物质能的论文(84)

关于生物质能的论文(45)

关于生物质能的论文(10)

100吨锅炉脱硝成功案例脱硝厂家

生物质锅炉除尘器规格

热风炉脱硝生物质锅炉脱硝环保设备

厂家介绍中频炉/生物质锅炉除尘器、降温器

布达拉宫在我眼中流淌

口语全真模拟考试报名 | 知名教师为你现场测试口语

河北股权交易所挂牌企业

同期活动丨欢迎参加中美环保企业对接会

独家丨中企海外项目周报(8.2-8.8)

企业碳讯丨好丽友发布双碳成果;

解构GTF2022丨史炜:航改燃机助力“双碳”目标

山东省新一轮“四减四增”三年行动方案
汇总 | 制药人都想要的一份专业知识整理

蒸汽发生器水质管理规定!

生物质锅炉除尘器阻火器

30吨生物质锅炉除尘器的内部结构,外部结构

高分子干法脱硝生物质锅炉脱硝

45吨生物质锅炉布袋除尘器的性能保证值

15吨生物质锅炉除尘器操作时的注意事项

10吨生物质锅炉布袋除尘器的安装及检修工作要求